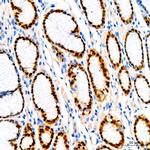
SOX9 Antibody in Immunohistochemistry (Paraffin) (IHC (P))

Search
Invitrogen
SOX9 Recombinant Rabbit Monoclonal Antibody (5Y4J8)
{{$productOrderCtrl.translations['antibody.pdp.commerceCard.promotion.promotions']}}
{{$productOrderCtrl.translations['antibody.pdp.commerceCard.promotion.viewpromo']}}
{{$productOrderCtrl.translations['antibody.pdp.commerceCard.promotion.promocode']}}: {{promo.promoCode}} {{promo.promoTitle}} {{promo.promoDescription}}. {{$productOrderCtrl.translations['antibody.pdp.commerceCard.promotion.learnmore']}}

Please note: We are reviewing Western blot images included in the antibody testing data in our catalog, including those provided by third parties. Unless expressly labeled or annotated as “raw-unedited”, Western blot images included in the antibody testing data in our catalog may have been edited, optimized or otherwise adjusted for presentation.
产品信息
MA5-42728
种属反应
宿主/亚型
Expression System
分类
类型
克隆号
抗原
偶联物
形式
浓度
规格
纯化类型
保存液
内含物
保存条件
运输条件
RRID
产品详细信息
Positive test controls include: HepG2, HeLa. The target is usually found in the following locations: Nucleus.
Immunogen sequence: HPDYKYQPRR RKSVKNGQAE AEEATEQTHI SPNAIFKALQ ADSPHSSSGM SEVHSPGEHS GQSQGPPTPP TTPKTDVQPG KADLKREGRP LPEGGRQPPI DFRDVDIGEL SSDVISNIET FDVNEFDQYL PP
靶标信息
SOX9 has a role in sex determination and differentiation of Sertoli cells. It is involved in chondrogenesis and regulates the expression of other genes involved in chondrogenesis by acting as a transcription factor for these genes. Translocation of this gene can cause campomelic dysplasia. SOX9 is involved in the formation of testes from the indifferent fetal gonads. It is a major molecular component of the neuron-glia switch in developing spinal cord. During normal development, SOX9 allows the prostate epithelium to outgrow into the mesenchyme and then provides basal cell support for development and maintenance of the luminal epithelium. These functions of SOX9 are subverted in prostate cancer to support tumor growth and invasion. SOX9 may direct the formation of neural crest precursors and the development of a range of neural crest derivative. It has a transcriptional regulation in melanin production in cells. Northern blot analysis shows its expression on adult testis, adult heart, and fetal brain.
仅用于科研。不用于诊断过程。未经明确授权不得转售。
篇参考文献 (0)
生物信息学
蛋白别名: mSox9; SOX 9; SRY (sex determining region Y)-box 9; SRY (sex determining region Y)-box 9 (campomelic dysplasia, autosomal sex-reversal); SRY-Box 9 ; SRY-box containing gene 9; Transcription factor SOX-9
基因别名: 2010306G03Rik; AV220920; mKIAA4243; Sox-9; SOX9
UniProt ID: (Rat) F1LYL9, (Mouse) Q04887
Entrez Gene ID: (Rat) 140586, (Mouse) 20682




